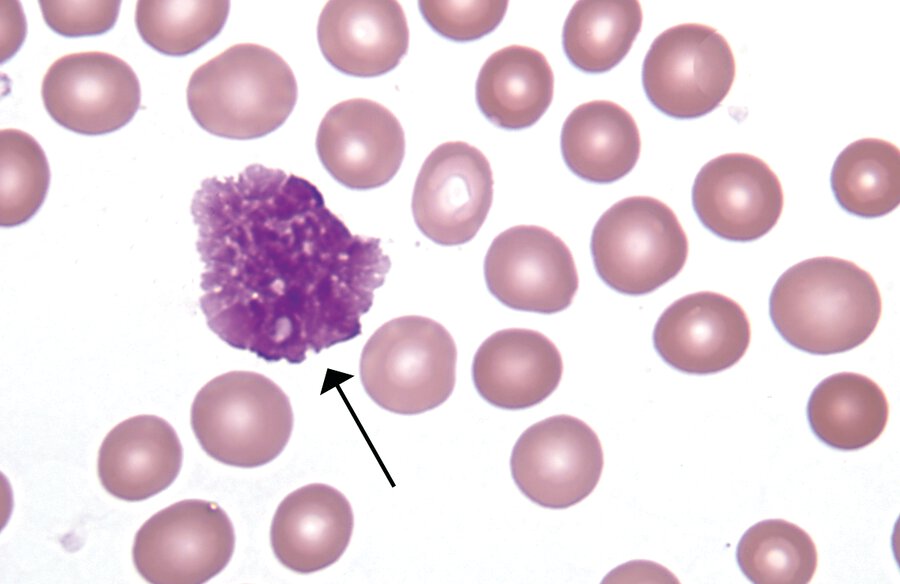
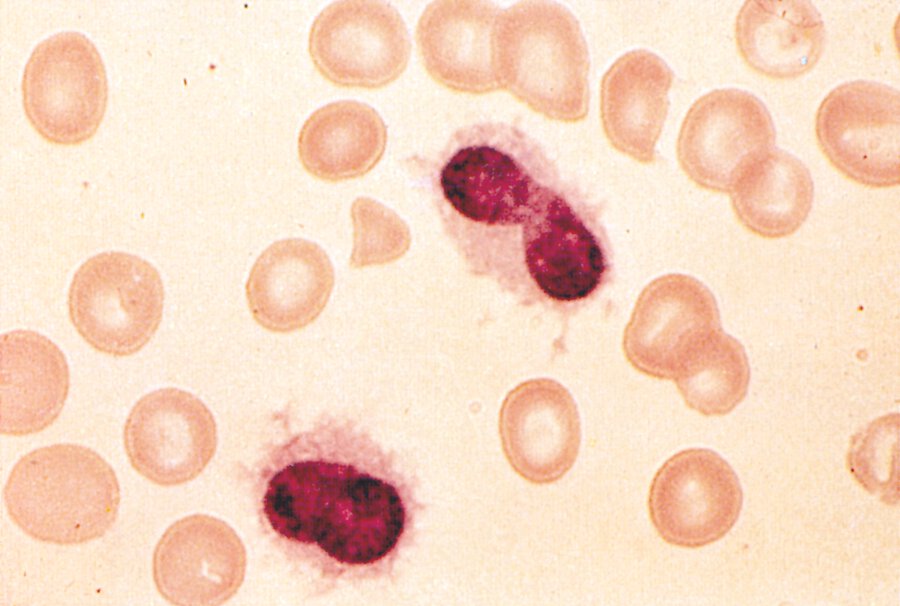

Preferred method of lymph node biopsy
Excisional
Type of cells with large bilobed nucleus and prominent eosinophilic nucleoli
Reed-Sternberg
Squamous cell carcinoma is the histologic type in what percent of cervical cancer?
69%
Nice.
Next diagnostic test in patient with CT pathognomonic for Renal Cell Cancer
Nothing
Name the ABCDE's
Asymmetry, Border irregularity, Color, Diameter, and Evolution
Where are the 7 institutions of the EU located? (4 cities)
Brussels, Strasbourg, Frankfurt, and Luxembourg City
Breast Implants have reported to be associated with what T-cell Lymphoma
Anaplastic Large Cell
Name the mutation in Mantle Cell Lymphoma
t(11:14)
Most cervical cancer is caused by what?
HPV
Mainstay of therapy for metastatic prostate disease
Androgen Deprivation
Cutoff depth for a thin melanoma
Breslow Depth <0.8mm
Name the coldest recorded temperature in Iowa
-47F in Washta, IA
Smudge Cell - seen in CLL
What stage of Hodgkin Lymphoma receives chemotherapy?
All
Most common symptoms of cervical cancer
Abnormal/heavy vaginal bleeding
Lab tests needed when concerned for testicular cancer
Alpha-fetoprotein and Beta-human chorionic gonadotropin
Life-long Melanoma follow-up skin exams should happen how often
6 Months
Name the country that has won the most Winter Olympic Medals
Norway (USA is #1 in Summer and Total Though)
Non-chemo treatment for double-hit lymphoma
Hematopoietic stem cell transplant
Hairy Cell
Tests to Dx Cervical Cancer
Biopsy, Colposcopy, or Cone biopsy
Most common method of testicular cancer Dx
Radical Inguinal Orchiectomy
Half of melanomas have what gene mutation?
BRAF (will accept mitogen-activated protein kinase pathway)
MEK or NRAS account for additional 20%
Where does Gretchen Wilson keep her Christmas lights all year long?
The Front Porch
What Hodgkin's Lymphoma drug causes lung injury
Bleomycin
Gene characteristic for Burkitt Lymphoma
MYC activation
How often do you get cervical cytology in cervical cancer survivors?
Annually
Treatment for non-invasive bladder cancer
TURBT (resection) and intravesical chemo
Can you use ipilimumab and nivolumab combo in BRAF-mutated melanoma?
Yes, you can also use it without BRAF-mutation
Tatanka is the Lakota word for what?
Bison